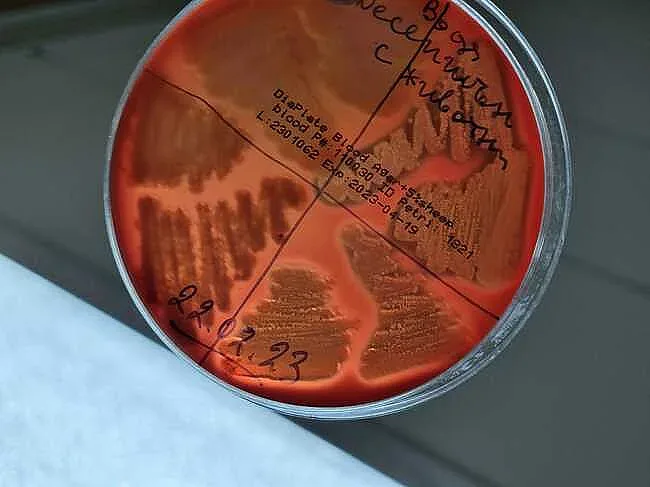

Освобождаването на древни патогени от топящите се ледове и вечна замръзналост може да причини големи екологични щети и мащабна загуба на организми гостоприемници, предупреждават учени, цитирани от ДПА.
Изследователи от Съвместния изследователски център на Европейската комисия и университета "Флиндърс" в Австралия направиха симулирани експерименти, при които дигитални патогени от миналото нахлуват в общности от бактериални гостоприемници. Компютърните симулации показват, че патогените могат да оцелеят и да се развиват в съвременния свят, като около 3% стават доминиращи в новата си среда.
Около 1% от тези нашественици предизвикват непредвидими резултати - някои причиняват измирането на до една трета от видовете гостоприемници, докато други увеличават разнородността си с до 12% в сравнение със симулациите, при които бягство не е разрешено.
Въпреки че 1% може да изглежда малко, "самият брой" древни микроби, редовно освобождавани в съвременните общности, означава, че огнищата представляват значителна опасност, каза водещият автор Джовани Строна.
"Открихме, че нахлуващите патогени често могат да оцелеят, да се развиват и в някои случаи да станат изключително устойчиви и доминиращи в общността, причинявайки или значителни загуби, или промени в броя на живите видове", каза Строна. "Следователно нашите открития предполагат, че непредсказуемите заплахи, които досега са ограничени до научната фантастика, в действителност биха могли да представляват сериозен риск като мощни двигатели на екологични щети."
В най-лошия случай инвазията на единичен древен патоген намалява размера на общността му гостоприемник с 30% в сравнение с неинвазивните видове.
Последвайте ни в Google News Showcase за важните новини
Вижте всички актуални новини от Standartnews.com